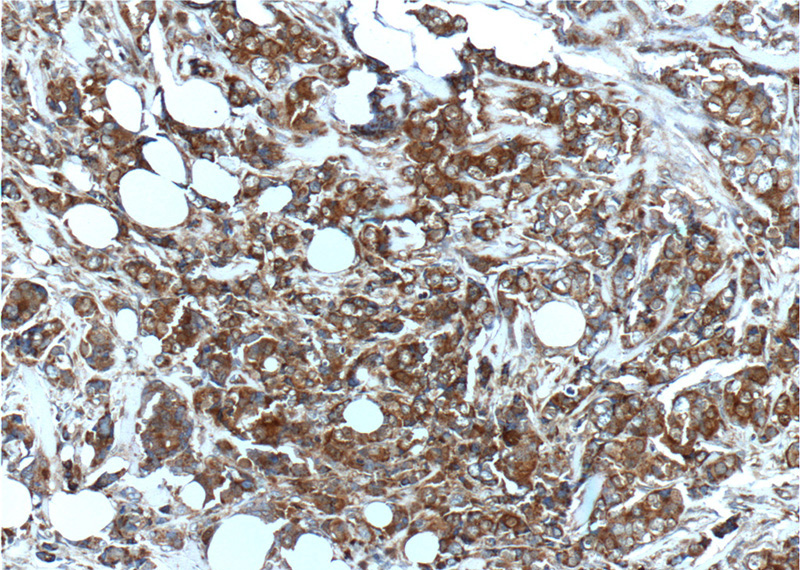

-
Product Name
S100A4 antibody
- Documents
-
Description
S100A4 Rabbit Polyclonal antibody. Positive WB detected in HeLa cells, NIH/3T3 cells. Positive IHC detected in human breast cancer tissue, human colon cancer tissue, human pancreas cancer tissue. Observed molecular weight by Western-blot: 10-12 kDa
-
Tested applications
ELISA, WB, IHC
-
Species reactivity
Human, Mouse; other species not tested.
-
Alternative names
18A2 antibody; 42A antibody; Calvasculin antibody; CAPL antibody; Fibroblast Specific Protein antibody; FSP1 antibody; Metastasin antibody; MTS1 antibody; P9KA antibody; PEL98 antibody; Protein Mts1 antibody; Protein S100 A4 antibody; S100A4 antibody
-
Isotype
Rabbit IgG
-
Preparation
This antibody was obtained by immunization of S100A4 recombinant protein (Accession Number: NM_002961). Purification method: Antigen affinity purified.
-
Clonality
Polyclonal
-
Formulation
PBS with 0.1% sodium azide and 50% glycerol pH 7.3.
-
Storage instructions
Store at -20℃. DO NOT ALIQUOT
-
Applications
Recommended Dilution:
WB: 1:200-1:2000
IHC: 1:50-1:500
-
Validations

HeLa cells were subjected to SDS PAGE followed by western blot with Catalog No:114961(S100A4 antibody) at dilution of 1:500
Immunohistochemistry of paraffin-embedded human breast cancer tissue slide using Catalog No:114961(S100A4 Antibody) at dilution of 1:200 (under 10x lens).

Immunohistochemistry of paraffin-embedded human breast cancer tissue slide using Catalog No:114961(S100A4 Antibody) at dilution of 1:200 (under 40x lens).
-
Background
S100A4 is a member of the S100 family of calcium-binding proteins. The S100 family members have been involved in the regulation of a number of cellular processes such as cell cycle progression and differentiation. S100A4 is known to localize to and function in the nucleus, cytoplasm of cells, and the extracellular space. S100A4 has also been shown to be associated with tumor growth, motility, invasion, metastasis, angiogenesis, apoptosis, and chemoresistance. It is a fibroblast-specific protein associated with mesenchymal cell morphology and motility, is expressed during epithelial-mesenchymal transformations (EMT) in vivo (PMID: 9362334). It is a specific prognostic marker for renal survival in patients with IgAN (PMID: 16105038). It is also an improved marker for lung fibroblasts that could be useful for investigating the pathogenesis of pulmonary fibrosis(PMID: 15618458). Overexpression of S100A4 is correlated with a worse prognosis inpatients with various types of cancer.
-
References
- Liu S, Li L, Zhang Y. The oncoprotein HBXIP uses two pathways to up-regulate S100A4 in promotion of growth and migration of breast cancer cells. The Journal of biological chemistry. 287(36):30228-39. 2012.
- Zhang Y, Zhao Y, Li H. The nuclear import of oncoprotein hepatitis B X-interacting protein depends on interacting with c-Fos and phosphorylation of both proteins in breast cancer cells. The Journal of biological chemistry. 288(26):18961-74. 2013.
- Shi Z, Shen T, Liu Y, Huang Y, Jiao J. Retinoic acid receptor γ (Rarg) and nuclear receptor subfamily 5, group A, member 2 (Nr5a2) promote conversion of fibroblasts to functional neurons. The Journal of biological chemistry. 289(10):6415-28. 2014.
- Yin L, Coelho SG, Ebsen D. Epidermal gene expression and ethnic pigmentation variations among individuals of Asian, European and African ancestry. Experimental dermatology. 23(10):731-5. 2014.
Related Products / Services
Please note: All products are "FOR RESEARCH USE ONLY AND ARE NOT INTENDED FOR DIAGNOSTIC OR THERAPEUTIC USE"
